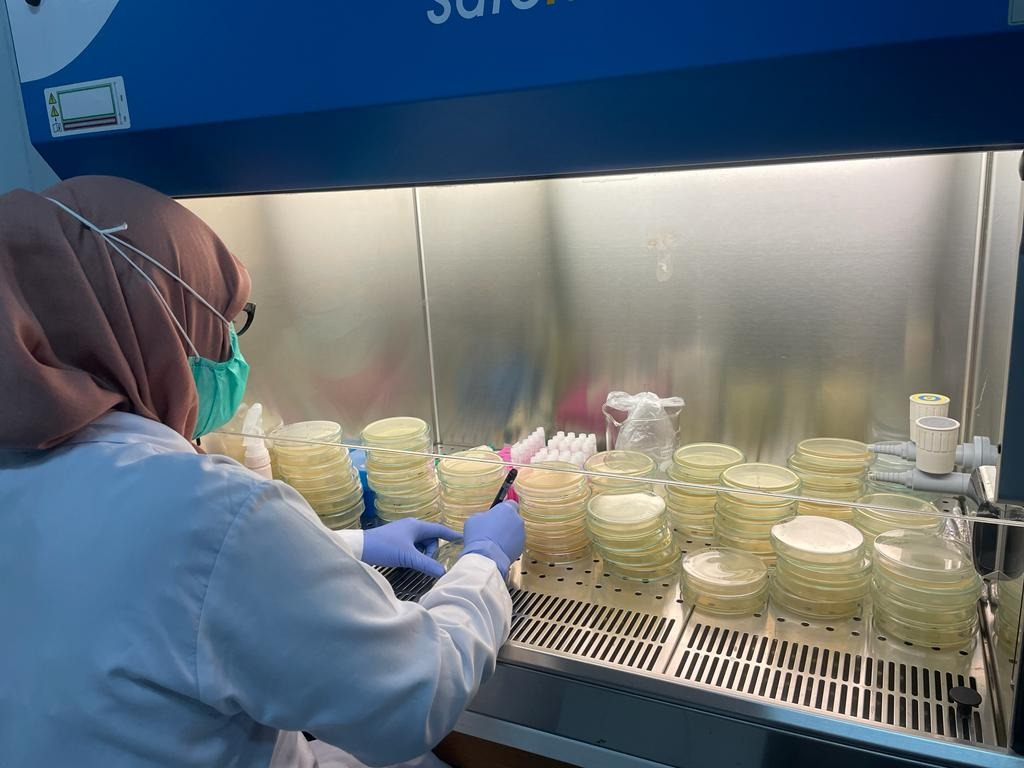

The history of the birth of the Microbiology Section cannot be separated from the history of the establishment of the Faculty of Medicine, Syiah Kuala University. The Faculty of Medicine, Syiah Kuala University was officially recognized as an institution providing medical education on April 1, 1982 by the Minister of Education and Culture Prof. Dr. Daoed Joesoef who delivered the Decree of the President of the Republic of Indonesia No. 16 of 1982 concerning the Organizational Structure of Syiah Kuala University which among other things stated that the Faculty of Medicine was part of Syiah Kuala University.
The Microbiology Section is the section that has the task of developing and implementing the Tri Dharma of Higher Education in the field of microbiology. The Microbiology Section is in charge of learning in the field of microbiology and infectious diseases in various study programs from several faculties at Syiah Kuala University. The Microbiology section supports various research related to the disciplines of microbiology and infectious diseases. The Microbiology Division also strives to participate in microbiology services in the community/community and in hospitals.
In order to increase the capacity of laboratories to support the process of education, research and outreach to the community, several Peer Research Groups in the Microbiology Division were formed, namely:
1. Peer group emerging and reemerging infectious diseases
2. Group tropical infection and molecular biology
3. Peer group multidrug resistant organisms and antimicrobial resistant
4. Peer group tuberculosis and leprosy
5. Peer group environmental microbiology and epidemiology
6. Peer group mycology, normal flora and other infections